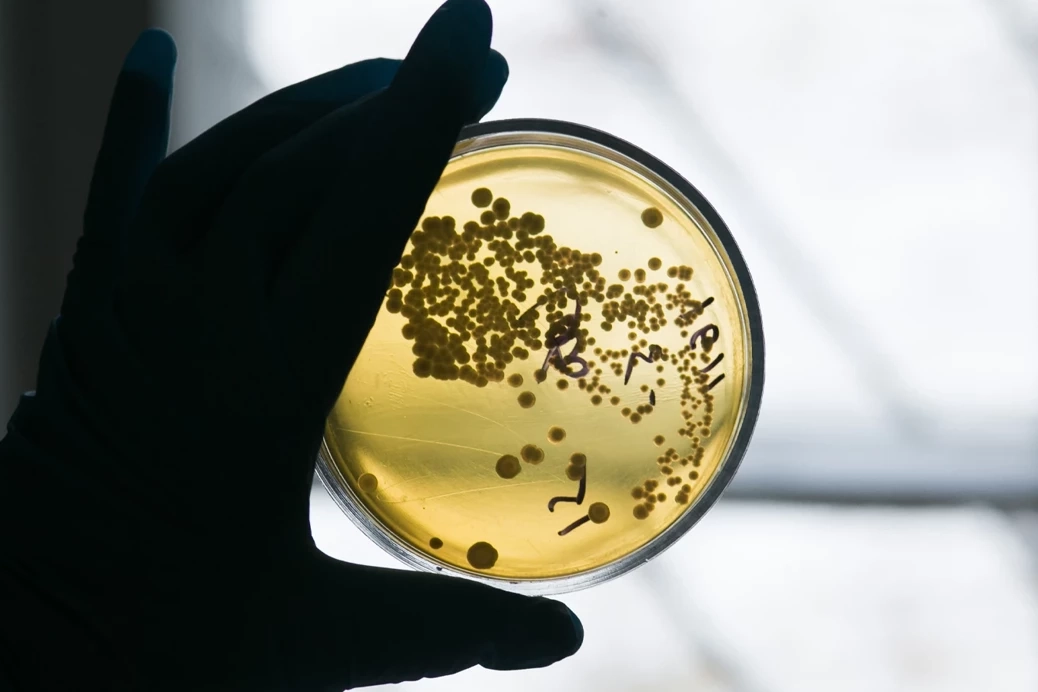

Robert Koch Enstitüsünün (RKI) yayımladığı rapora göre, bir erkek çocuk ile bir kadının E.Coli salgınında öldüğü ifade edildi.
Söz konusu iki kişinin, E. Coli bakterisine bağlı böbrek yetmezliği nedeniyle hayatını kaybettiği bildirildi.
Ayrıca yine 90 yaşında bir kişinin salgınla bağlantılı olarak hayatını kaybettiği ancak vakanın tam olarak teyit edilmediği belirtildi.
RKI'ya göre özellikle 10 yaşın altındaki çocuklar mevcut salgından daha fazla etkileniyor.
22 Ekim itibarıyla salgında 183 vakanın tespit edildiği, diğer 168 vakada ise E. Coli şüphesi bulunduğu ancak net teşhisin konulmadığı raporda yer aldı.